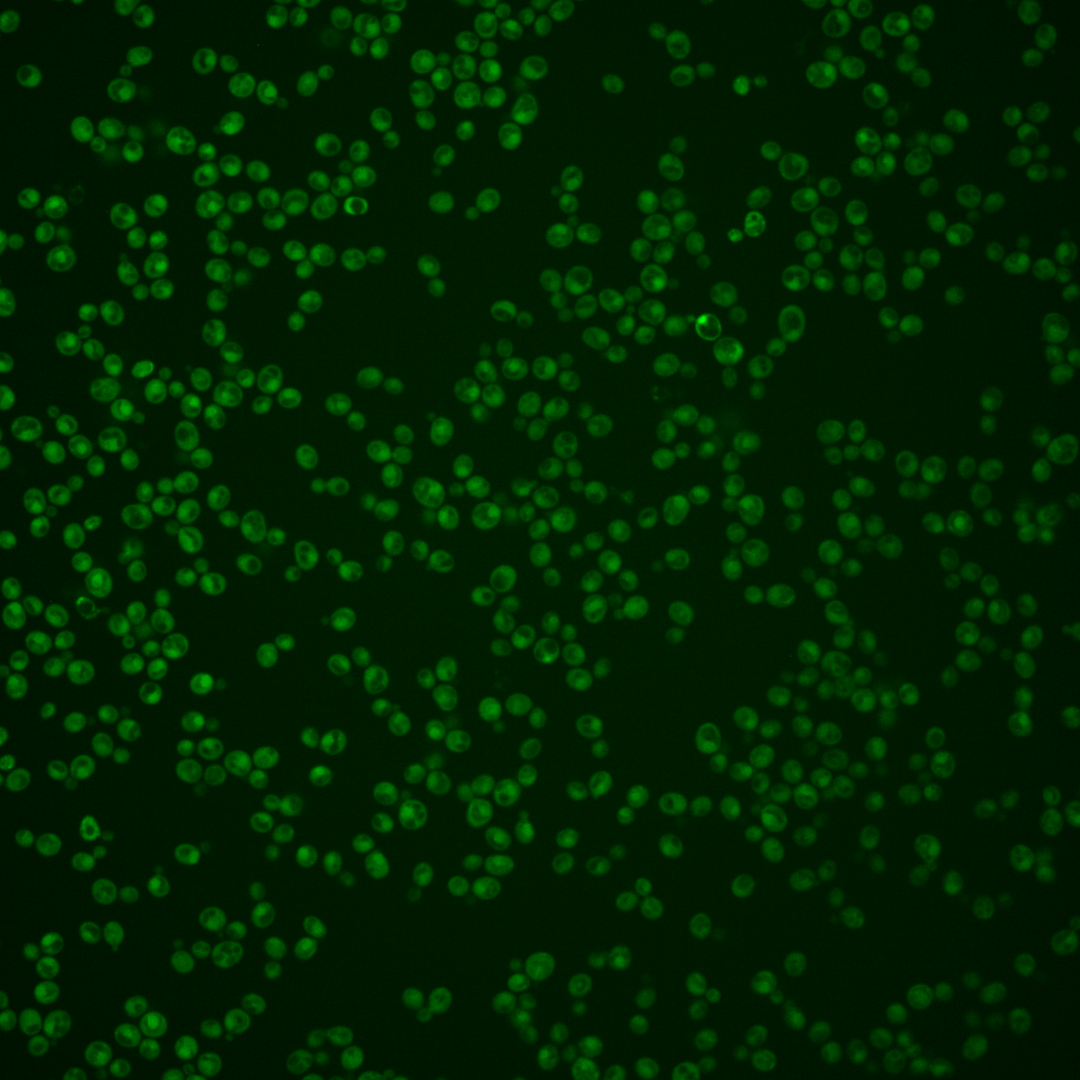
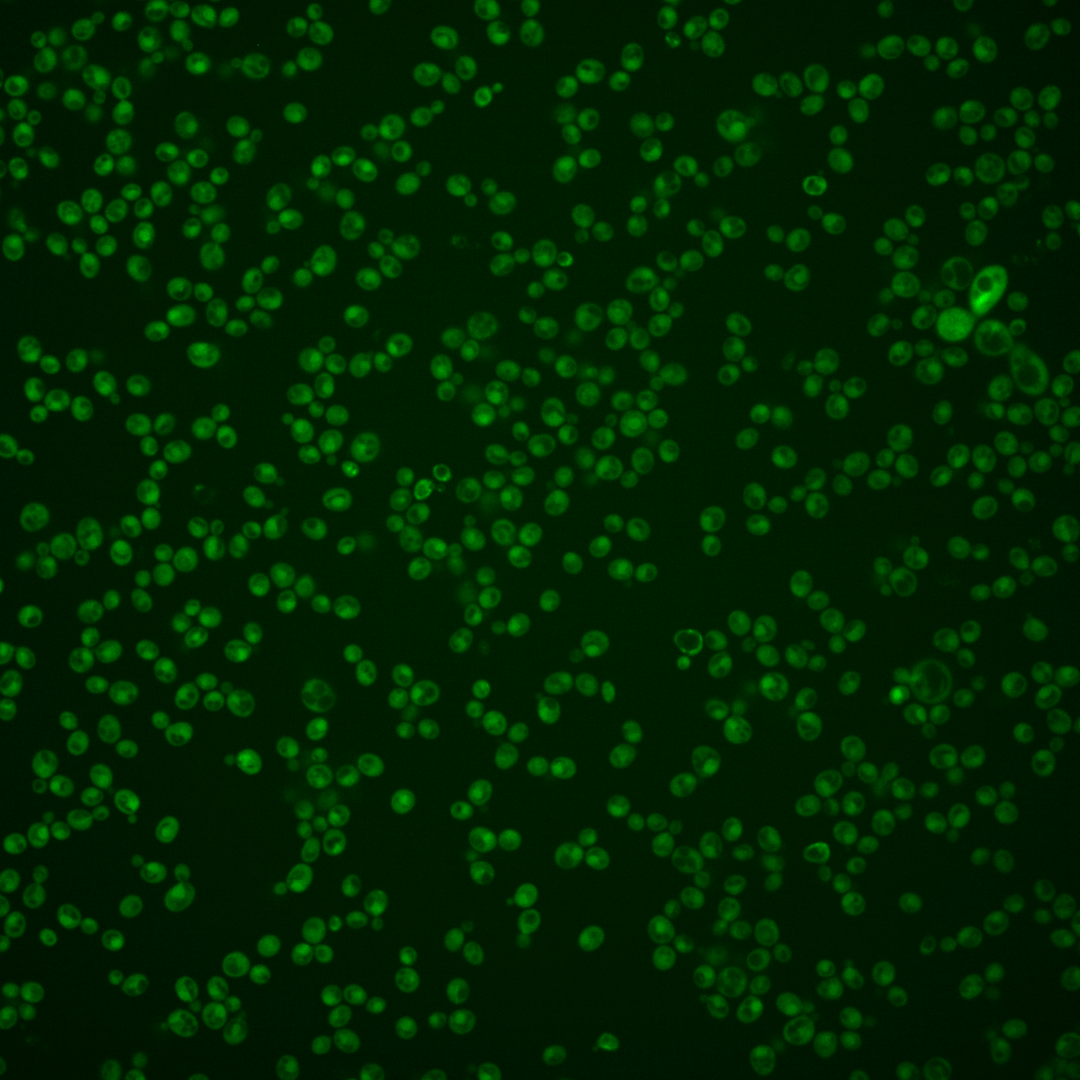
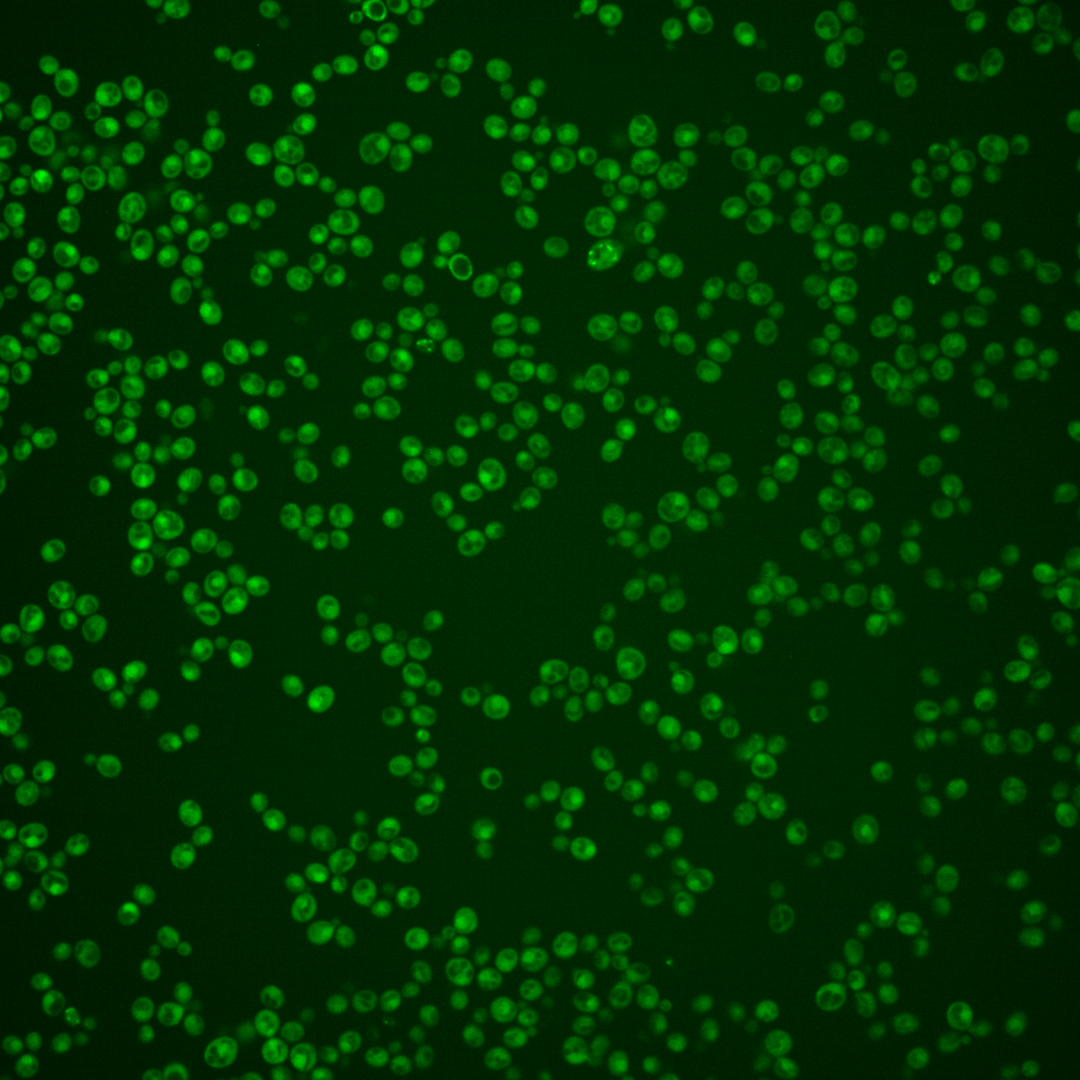
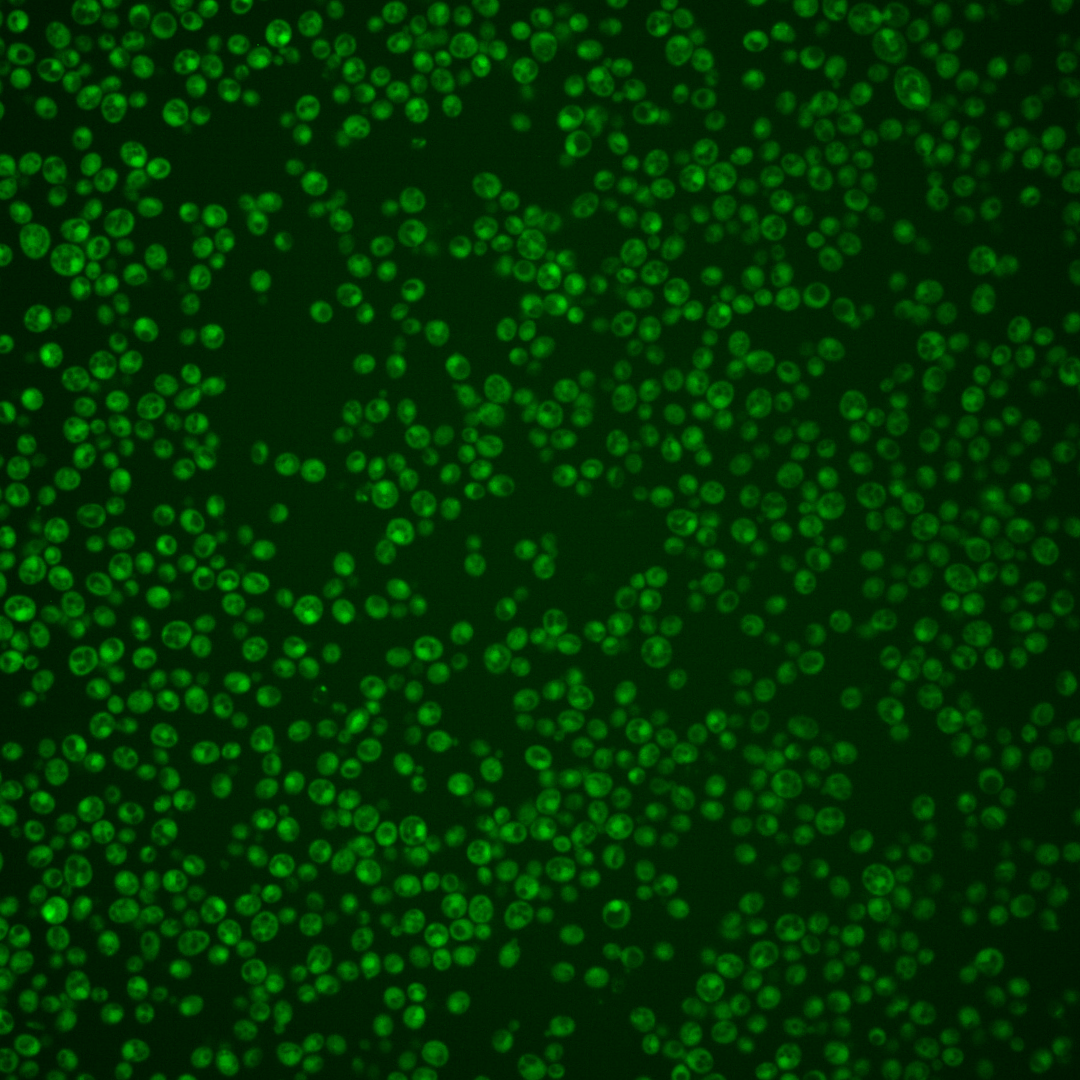
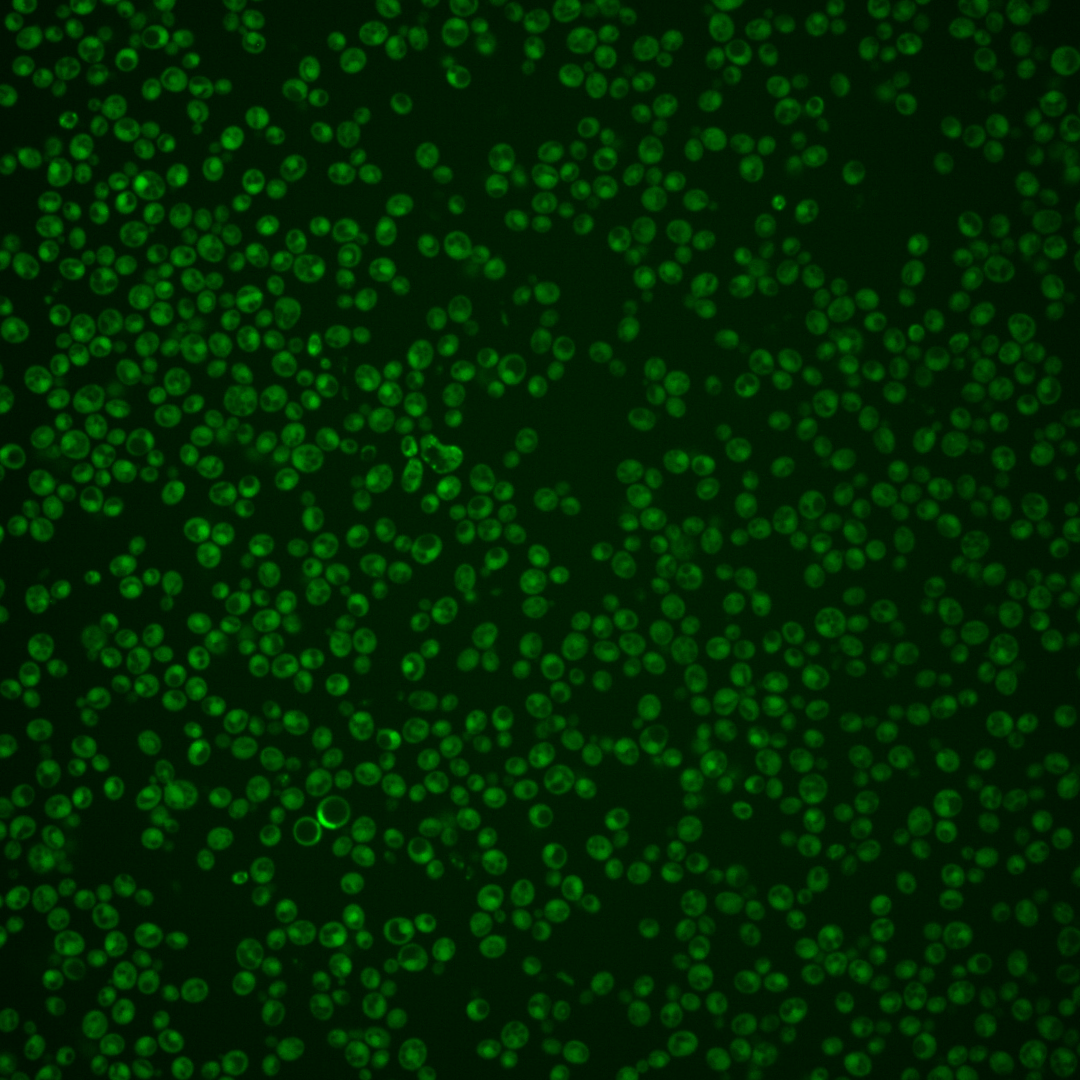

| Standard name | |
|---|---|
| Human Ortholog | |
| Description | Protein with a possible role in phospholipid biosynthesis; null mutant displays an inositol-excreting phenotype that is suppressed by exogenous choline; protein abundance increases in response to DNA replication stress |
Micrographs




















































































Sub-cellular Localization
Yeast GFP Assignment
Protein Abundance
Localization Change
External localization resources
| ensLOC | DeepLoc | |||||||||||||||||||||||
|---|---|---|---|---|---|---|---|---|---|---|---|---|---|---|---|---|---|---|---|---|---|---|---|---|
| Localization | WT1 | WT2 | WT3 | RAP60 | RAP140 | RAP220 | RAP300 | RAP380 | RAP460 | RAP540 | RAP620 | RAP700 | HU80 | HU120 | HU160 | rpd3Δ_1 | rpd3Δ_2 | rpd3Δ_3 | WT1 | WT2 | WT3 | AF100 | AF140 | AF180 |
| Cortical Patches | 0 | 0 | 1 | 0 | 0 | 0 | 0 | 0 | 0 | 1 | 0 | 0 | 0 | 0 | 0 | 1 | 0 | 0 | 0 | 0 | 2 | 0 | 2 | 3 |
| Bud | 0 | 0 | 1 | 0 | 1 | 4 | 5 | 8 | 8 | 4 | 4 | 6 | 0 | 0 | 0 | 0 | 0 | 1 | 0 | 5 | 9 | 1 | 5 | 15 |
| Bud Neck | 0 | 0 | 0 | 0 | 0 | 0 | 0 | 0 | 0 | 0 | 0 | 1 | 0 | 0 | 0 | 0 | 0 | 0 | 0 | 3 | 2 | 1 | 1 | 4 |
| Bud Site | 0 | 0 | 0 | 0 | 1 | 1 | 0 | 0 | 1 | 0 | 0 | 0 | 0 | 0 | 0 | 0 | 0 | 0 | – | – | – | – | – | – |
| Cell Periphery | 0 | 0 | 1 | 0 | 0 | 0 | 1 | 4 | 2 | 2 | 0 | 1 | 0 | 0 | 0 | 1 | 2 | 0 | 0 | 0 | 0 | 0 | 0 | 0 |
| Cytoplasm | 67 | 165 | 232 | 138 | 210 | 258 | 261 | 220 | 215 | 236 | 167 | 186 | 81 | 112 | 138 | 77 | 87 | 85 | 85 | 157 | 270 | 57 | 179 | 192 |
| Endoplasmic Reticulum | 1 | 2 | 2 | 0 | 3 | 2 | 2 | 2 | 3 | 4 | 2 | 2 | 4 | 0 | 3 | 2 | 2 | 4 | 0 | 0 | 26 | 1 | 11 | 10 |
| Endosome | 0 | 1 | 6 | 8 | 7 | 5 | 9 | 2 | 7 | 2 | 3 | 11 | 0 | 1 | 3 | 0 | 2 | 1 | 1 | 1 | 16 | 0 | 10 | 16 |
| Golgi | 1 | 0 | 1 | 0 | 0 | 0 | 0 | 0 | 0 | 0 | 0 | 1 | 0 | 0 | 0 | 1 | 0 | 3 | 1 | 0 | 1 | 0 | 1 | 0 |
| Mitochondria | 3 | 5 | 12 | 22 | 23 | 106 | 199 | 171 | 174 | 178 | 181 | 142 | 0 | 0 | 0 | 3 | 3 | 1 | 1 | 3 | 4 | 4 | 20 | 11 |
| Nucleus | 4 | 6 | 8 | 13 | 42 | 36 | 67 | 65 | 89 | 107 | 81 | 85 | 5 | 5 | 0 | 2 | 5 | 6 | 25 | 49 | 53 | 4 | 19 | 16 |
| Nuclear Periphery | 0 | 0 | 0 | 0 | 3 | 3 | 5 | 8 | 4 | 2 | 2 | 10 | 0 | 0 | 0 | 1 | 0 | 0 | 2 | 1 | 31 | 1 | 6 | 6 |
| Nucleolus | 1 | 0 | 0 | 0 | 0 | 2 | 7 | 6 | 2 | 3 | 3 | 4 | 0 | 0 | 0 | 0 | 0 | 0 | 0 | 0 | 0 | 0 | 0 | 0 |
| Peroxisomes | 0 | 0 | 0 | 0 | 0 | 0 | 0 | 0 | 0 | 0 | 0 | 0 | 0 | 0 | 0 | 0 | 0 | 0 | 0 | 0 | 0 | 1 | 0 | 0 |
| SpindlePole | 0 | 0 | 0 | 0 | 0 | 0 | 0 | 0 | 1 | 0 | 0 | 0 | 0 | 0 | 0 | 0 | 0 | 0 | 2 | 2 | 8 | 1 | 6 | 9 |
| Vac/Vac Membrane | 50 | 93 | 258 | 198 | 288 | 263 | 406 | 322 | 387 | 390 | 263 | 371 | 26 | 89 | 108 | 103 | 114 | 109 | 16 | 23 | 37 | 10 | 52 | 63 |
| Unique Cell Count | 111 | 243 | 444 | 326 | 503 | 583 | 791 | 694 | 755 | 785 | 596 | 687 | 106 | 182 | 227 | 169 | 184 | 181 | 139 | 256 | 478 | 89 | 327 | 359 |
| Labelled Cell Count | 127 | 272 | 522 | 379 | 578 | 680 | 962 | 808 | 893 | 929 | 706 | 820 | 116 | 207 | 252 | 191 | 215 | 210 | 139 | 256 | 478 | 89 | 327 | 359 |
Yeast GFP Assignment
Protein Abundance
| Screen | WT1 | WT2 | WT3 | RAP60 | RAP140 | RAP220 | RAP300 | RAP380 | RAP460 | RAP540 | RAP620 | RAP700 | HU80 | HU120 | HU160 | rpd3Δ_1 | rpd3Δ_2 | rpd3Δ_3 | AF100 | AF140 | AF180 |
|---|---|---|---|---|---|---|---|---|---|---|---|---|---|---|---|---|---|---|---|---|---|
| Mean Cell GFP Intensity (1e-4) | 6.1 | 5.9 | 6.6 | 6.1 | 6.6 | 6.2 | 6.7 | 6.7 | 7.6 | 7.5 | 7.9 | 8.2 | 6.1 | 7.0 | 7.6 | 8.8 | 8.8 | 8.6 | – | 6.4 | 7.1 |
| Std Deviation (1e-4) | 1.6 | 1.1 | 1.7 | 1.4 | 1.5 | 1.8 | 2.0 | 1.8 | 2.2 | 2.3 | 2.7 | 2.8 | 1.2 | 1.5 | 1.1 | 3.0 | 2.0 | 3.0 | – | 1.2 | 1.4 |
| Intensity Change (Log2) | – | – | – | -0.11 | -0.02 | -0.09 | 0.01 | 0.02 | 0.2 | 0.18 | 0.25 | 0.3 | -0.11 | 0.08 | 0.2 | 0.41 | 0.41 | 0.38 | – | -0.04 | 0.1 |
Localization Change
| Localization | RAP60 | RAP140 | RAP220 | RAP300 | RAP380 | RAP460 | RAP540 | RAP620 | RAP700 | HU80 | HU120 | HU160 | rpd3Δ_1 | rpd3Δ_2 | rpd3Δ_3 |
|---|---|---|---|---|---|---|---|---|---|---|---|---|---|---|---|
| Cortical Patches | 0 | 0 | 0 | 0 | 0 | 0 | 0 | 0 | 0 | 0 | 0 | 0 | 0 | 0 | 0 |
| Bud | 0 | 0 | 0 | 0 | 0 | 0 | 0 | 0 | 0 | 0 | 0 | 0 | 0 | 0 | 0 |
| Bud Neck | 0 | 0 | 0 | 0 | 0 | 0 | 0 | 0 | 0 | 0 | 0 | 0 | 0 | 0 | 0 |
| Bud Site | 0 | 0 | 0 | 0 | 0 | 0 | 0 | 0 | 0 | 0 | 0 | 0 | 0 | 0 | 0 |
| Cell Periphery | 0 | 0 | 0 | 0 | 0 | 0 | 0 | 0 | 0 | 0 | 0 | 0 | 0 | 0 | 0 |
| Cytoplasm | -2.7 | -3.2 | -2.5 | -6.6 | -6.9 | -8.2 | -7.7 | -7.9 | -8.6 | 4.5 | 2.1 | 2.1 | -1.5 | -1.1 | -1.2 |
| Endoplasmic Reticulum | 0 | 0 | 0 | 0 | 0 | 0 | 0 | 0 | 0 | 0 | 0 | 0 | 0 | 0 | 0 |
| Endosome | 1.1 | 0.1 | 0 | -0.3 | 0 | 0 | 0 | 0 | 0.3 | 0 | 0 | 0 | 0 | 0 | 0 |
| Golgi | 0 | 0 | 0 | 0 | 0 | 0 | 0 | 0 | 0 | 0 | 0 | 0 | 0 | 0 | 0 |
| Mitochondria | 2.7 | 1.5 | 7.7 | 10.1 | 9.8 | 9.4 | 9.3 | 11.4 | 8.6 | 0 | 0 | 0 | 0 | 0 | 0 |
| Nucleus | 1.8 | 4.5 | 3.4 | 4.7 | 5.1 | 6.1 | 6.8 | 6.7 | 6.3 | 0 | 0 | 0 | 0 | 0 | 0 |
| Nuclear Periphery | 0 | 0 | 0 | 0 | 0 | 0 | 0 | 0 | 0 | 0 | 0 | 0 | 0 | 0 | 0 |
| Nucleolus | 0 | 0 | 0 | 0 | 0 | 0 | 0 | 0 | 0 | 0 | 0 | 0 | 0 | 0 | 0 |
| Peroxisomes | 0 | 0 | 0 | 0 | 0 | 0 | 0 | 0 | 0 | 0 | 0 | 0 | 0 | 0 | 0 |
| SpindlePole | 0 | 0 | 0 | 0 | 0 | 0 | 0 | 0 | 0 | 0 | 0 | 0 | 0 | 0 | 0 |
| Vacuole | 0.7 | -0.3 | -4.1 | -2.3 | -3.9 | -2.3 | -2.8 | -4.5 | -1.4 | -6.2 | -2.1 | -2.6 | 0.6 | 0.9 | 0.5 |
External localization resources
Images






























Protein Concentration and Protein Localization Data
| R1 | R2 | R3 | ||||||||||||||||
|---|---|---|---|---|---|---|---|---|---|---|---|---|---|---|---|---|---|---|
| G1 Pre-START | G1 Post-START | S/G2 | Metaphase | Anaphase | Telophase | G1 Pre-START | G1 Post-START | S/G2 | Metaphase | Anaphase | Telophase | G1 Pre-START | G1 Post-START | S/G2 | Metaphase | Anaphase | Telophase | |
| Concentration | -0.2989 | 0.1636 | 0.0824 | -0.2531 | -0.2533 | 0.1898 | 1.4756 | 1.8449 | 1.6052 | 1.0876 | 1.4688 | 1.7665 | 0.2016 | 0.683 | 0.4367 | 0.2948 | 0.549 | 0.314 |
| Actin | 0.0063 | 0.0009 | 0.0006 | 0.0005 | 0.0146 | 0.0017 | 0.0067 | 0.0015 | 0.008 | 0.0332 | 0.0288 | 0.0014 | 0.017 | 0.0001 | 0.0029 | 0.0009 | 0.0085 | 0.0049 |
| Bud | 0.0001 | 0.0005 | 0.0002 | 0.0001 | 0.0015 | 0.0001 | 0.0004 | 0.0017 | 0.0011 | 0.0003 | 0.0003 | 0.0008 | 0.0002 | 0 | 0.0003 | 0.0001 | 0.0009 | 0.0006 |
| Bud Neck | 0.0007 | 0.0005 | 0.0003 | 0.0007 | 0.0009 | 0.001 | 0.005 | 0.0003 | 0.0007 | 0.0021 | 0.0008 | 0.0017 | 0.0009 | 0.0001 | 0.0003 | 0.0002 | 0.0004 | 0.0004 |
| Bud Periphery | 0.0001 | 0.0003 | 0.0001 | 0.0001 | 0.0038 | 0 | 0.0004 | 0.0013 | 0.0008 | 0.0004 | 0.0002 | 0.0016 | 0.0002 | 0 | 0.0006 | 0.0001 | 0.0006 | 0.005 |
| Bud Site | 0.0002 | 0.0112 | 0.0005 | 0.0002 | 0.0088 | 0.0001 | 0.0073 | 0.0047 | 0.0069 | 0.0013 | 0.0006 | 0.0002 | 0.0016 | 0.0004 | 0.0006 | 0.0002 | 0.0018 | 0.0001 |
| Cell Periphery | 0.0001 | 0.0001 | 0.0001 | 0 | 0.0002 | 0 | 0.0002 | 0.0001 | 0.0001 | 0.0001 | 0 | 0 | 0.0002 | 0.0001 | 0.0001 | 0.0001 | 0 | 0.0001 |
| Cytoplasm | 0.5047 | 0.5257 | 0.5228 | 0.5088 | 0.4573 | 0.5247 | 0.4534 | 0.539 | 0.547 | 0.3922 | 0.3769 | 0.5858 | 0.4723 | 0.6368 | 0.5444 | 0.5598 | 0.3479 | 0.4993 |
| Cytoplasmic Foci | 0.01 | 0.0126 | 0.0079 | 0.0124 | 0.0075 | 0.0112 | 0.0162 | 0.0084 | 0.0093 | 0.0099 | 0.0275 | 0.0107 | 0.0145 | 0.0079 | 0.0204 | 0.0066 | 0.0616 | 0.0083 |
| Eisosomes | 0.0001 | 0.0001 | 0.0001 | 0 | 0.0004 | 0 | 0.0002 | 0.0001 | 0.0001 | 0.0004 | 0.0001 | 0 | 0.0002 | 0 | 0.0001 | 0 | 0 | 0.0001 |
| Endoplasmic Reticulum | 0.0166 | 0.0088 | 0.0106 | 0.012 | 0.007 | 0.0079 | 0.0095 | 0.0079 | 0.0136 | 0.0078 | 0.0027 | 0.006 | 0.0272 | 0.0084 | 0.0083 | 0.0162 | 0.003 | 0.0063 |
| Endosome | 0.0097 | 0.0112 | 0.0071 | 0.0152 | 0.0123 | 0.0134 | 0.0125 | 0.006 | 0.0088 | 0.0073 | 0.0087 | 0.0057 | 0.0161 | 0.0037 | 0.0119 | 0.0174 | 0.0734 | 0.0083 |
| Golgi | 0.0003 | 0.0006 | 0.0002 | 0.0002 | 0.0015 | 0.0003 | 0.0015 | 0.0002 | 0.001 | 0.0016 | 0.0019 | 0.0001 | 0.0043 | 0.0001 | 0.0021 | 0.0004 | 0.0407 | 0.0069 |
| Lipid Particles | 0.0007 | 0.0008 | 0.0003 | 0.0006 | 0.0018 | 0.0006 | 0.002 | 0.0005 | 0.001 | 0.0012 | 0.0057 | 0.0001 | 0.0158 | 0.0004 | 0.002 | 0.0001 | 0.0041 | 0.01 |
| Mitochondria | 0.0004 | 0.0008 | 0.0007 | 0.0008 | 0.0046 | 0.0005 | 0.0011 | 0.0009 | 0.0018 | 0.0017 | 0.0009 | 0.0008 | 0.0043 | 0.0001 | 0.0019 | 0.001 | 0.0154 | 0.0149 |
| None | 0.3481 | 0.3451 | 0.3526 | 0.2713 | 0.3488 | 0.3167 | 0.3523 | 0.3466 | 0.3122 | 0.437 | 0.4086 | 0.2639 | 0.327 | 0.2974 | 0.3491 | 0.378 | 0.3608 | 0.4093 |
| Nuclear Periphery | 0.0193 | 0.0145 | 0.0145 | 0.0286 | 0.0121 | 0.0123 | 0.0216 | 0.0104 | 0.0154 | 0.0159 | 0.0031 | 0.011 | 0.0216 | 0.0111 | 0.0146 | 0.0079 | 0.0052 | 0.0055 |
| Nucleolus | 0.0003 | 0.0005 | 0.0003 | 0.0007 | 0.0035 | 0.0004 | 0.0013 | 0.0004 | 0.0009 | 0.0005 | 0.0003 | 0.0004 | 0.0008 | 0.0001 | 0.0002 | 0.0001 | 0.0002 | 0.0001 |
| Nucleus | 0.0731 | 0.0525 | 0.0708 | 0.1292 | 0.1 | 0.0964 | 0.0884 | 0.0623 | 0.0545 | 0.076 | 0.0705 | 0.0967 | 0.0585 | 0.0291 | 0.0265 | 0.0075 | 0.0364 | 0.0147 |
| Peroxisomes | 0.0001 | 0.0005 | 0.0002 | 0.0003 | 0.0026 | 0.0002 | 0.0022 | 0.0003 | 0.0005 | 0.002 | 0.0319 | 0.0002 | 0.0069 | 0 | 0.0021 | 0.0001 | 0.0341 | 0.0018 |
| Punctate Nuclear | 0.0055 | 0.0088 | 0.0059 | 0.0133 | 0.0066 | 0.0098 | 0.014 | 0.0051 | 0.0139 | 0.0071 | 0.0295 | 0.0107 | 0.0075 | 0.0024 | 0.0086 | 0.0009 | 0.0018 | 0.0009 |
| Vacuole | 0.003 | 0.0033 | 0.0037 | 0.0042 | 0.0034 | 0.0021 | 0.0032 | 0.0017 | 0.0019 | 0.0014 | 0.0008 | 0.0015 | 0.0025 | 0.0016 | 0.002 | 0.0016 | 0.0021 | 0.0011 |
| Vacuole Periphery | 0.0007 | 0.0006 | 0.0006 | 0.001 | 0.0008 | 0.0005 | 0.0006 | 0.0003 | 0.0006 | 0.0005 | 0.0002 | 0.0004 | 0.0007 | 0.0002 | 0.0013 | 0.0008 | 0.001 | 0.0013 |
Sequencing Data
| R1 | R2 | |||||||||
|---|---|---|---|---|---|---|---|---|---|---|
| G1 Post-START | S/G2 | Metaphase | Anaphase | Telophase | G1 Post-START | S/G2 | Metaphase | Anaphase | Telophase | |
| Gene Expression | 5.2118 | 2.6623 | 4.9388 | 10.97 | 9.6533 | 10.4178 | 10.4309 | 15.897 | 13.9883 | 10.7667 |
| Translational Efficiency | 2.3041 | 5.7792 | 2.3862 | 1.324 | 1.4096 | 1.9682 | 1.9655 | 1.2935 | 2.1908 | 1.9689 |
Hit Data
| Dataset | Hit |
|---|---|
| Protein Concentration | ✔ |
| Protein Localization | ✘ |
| Gene Expression | ✘ |
| Translational Efficiency | ✘ |
Endocytosis
| Temp | Actin Patch (Sac6-tdTomato) | Cortical Patch (Sla1-GFP) | Late Endosome (Snf7-GFP) | Vacuole (Vph1-GFP) |
|---|---|---|---|---|
| 37℃ | ||||
| RT |
Cell Cycle Omics
CYCLoPs (Opi10-GFP)
| Gene / Allele | Actin Patch (Sac6-tdTomato) | Cortical Patch (Sla1-GFP) | Late Endosome (Snf7-GFP) | Vacuole (Sac6-tdTomato) |
|---|
| Gene | Images |
|---|
| Gene | Images |
|---|
Images are not yet available
Images are not yet available